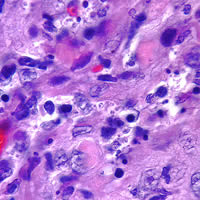
Case 72 Image B
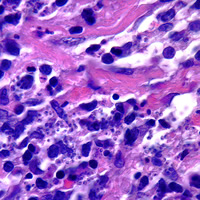
Case 72 Image C
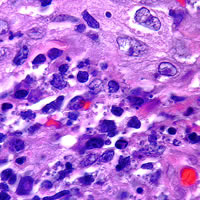
Case 72 Image D

|
Case
71
A 30-year-old woman discovered a worm in her stool (Figure A).
She took the specimen to her doctor, reporting no symptoms or international
travel. The specimen was preserved in 10% formalin and sent to
CDC for identification. The worm was identified using a dissecting
microscope. The laboratorians at CDC were also interested in determining
the gender of the worm. The anterior and posterior ends of the worm
were dissected and placed in lacto-phenol solution to clear the worm
so that morphologic/diagnostic features could be seen (posterior end—Figure B and Figure C; anterior end—Figure D and
Figure E). A frontal view of the anterior tip is pictured
in Figure F. What is your diagnosis? Based on what
criteria? For bonus points, what is the worm's gender?
 |
 |
| A |
B |
 |
 |
| C |
D |
 |
 |
| E |
F |
Click
here for the answer to Case 71.
Case
72
A sixteen-year-old teenage boy spent a month in the Amazon basin in Brazil. After returning
to the United States, he noticed a small indurated nodule on his forehead.
He treated the nodule with topical antibiotics. During the next
three months, the lesion did not heal, but became ulcerated and continued
to grow. The teenager visited his doctor who photographed the lesion
and performed a biopsy. Figure A is a photograph of the lesion
on the young man’s forehead. Figures B, C, and D
are Giemsa stained sections of the tissue that was sent to CDC for
identification/diagnosis. What is your diagnosis? Based on
what criteria?
 |
|
| A |
B |
|
|
| C |
D |
Click
here for the answer to Case 72.
Images presented
in the monthly case studies are from specimens submitted for diagnosis
or archiving. On rare occasions, clinical histories given may be
partly fictitious.
|